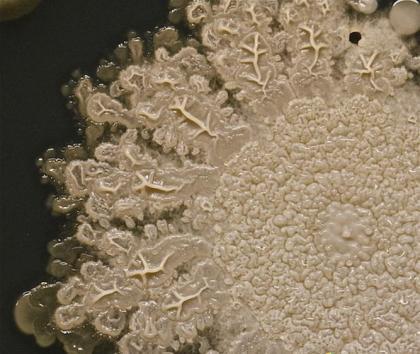

★公众号:寰宇科学(点击复制)微信
组图:太恐怖了!这是我们手上的细菌
2015-6-11 寰宇科学

健康专家告诫我们饭前洗手是非常有必要的!目前,微生物学家塔莎-斯特姆(Tasha Sturm)通过实验发现8岁儿子手掌上有大量细菌,其中最多的细菌种群是葡萄球菌,它们通常是无害的,存在于30%人类的鼻孔之中。如图所示,这是8岁儿童手掌上寄居的细菌。
这是儿童手掌上寄居最大的细菌种群——芽孢杆菌,它是一种杆状细菌。

为了准确地分析手掌中寄居着哪些细菌种群,微生物学家塔莎需要进行详细测试,她认为图中可能是葡萄球菌。

图中是手印外侧一种未识别的细菌种群,很可能是污染所致。

共有465阅 / 0评我要评论
发表你的评论吧返回顶部
!评论内容需包含中文
